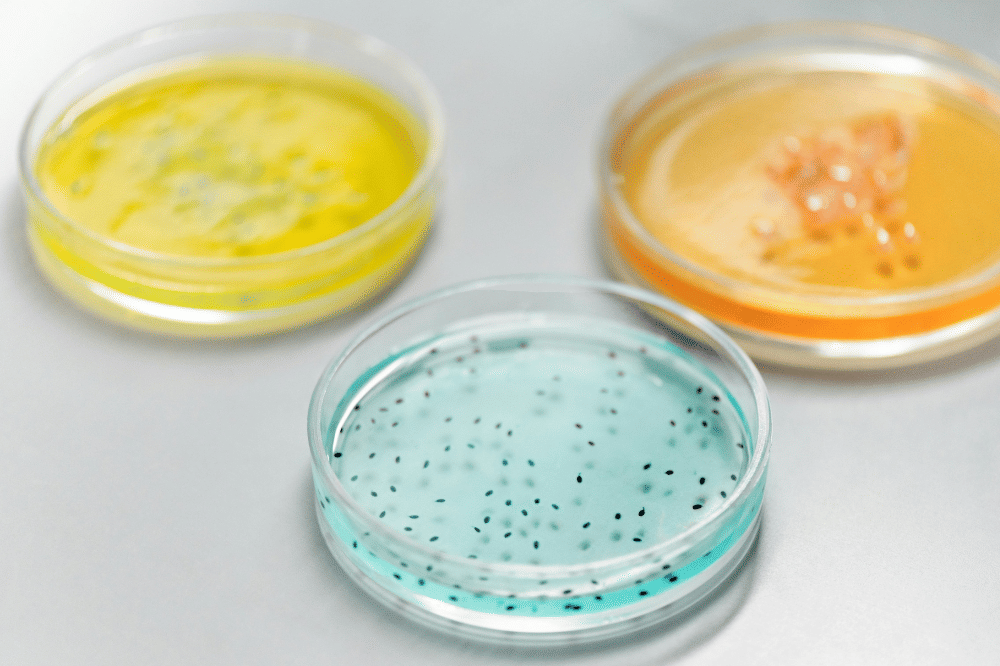
bakteri

Manfaat Bakteri Baik untuk Kesehatan Tubuh, Tak Selamanya Buruk!

- Bakteri bermanfaat bagi tubuh manusia, terutama dalam membantu pencernaan.
- Bakteri bekerja secara simbiosis di dalam tubuh (mikrobiota) yang melindungi dari bakteri jahat.
- Bakteri baik diperoleh dari makanan fermentasi, lingkungan, dan sejak lahir, seperti yogurt, tempe, serta kontak alami dengan lingkungan sekitar.
Bakteri sering disalahpahami hanya sebagai penyebab penyakit. Padahal banyak bakteri bermanfaat yang mempunyai peran penting dalam kehidupan manusia baik secara langsung di tubuh maupun dalam lingkungan sekitar kita.
Bakteri ini membantu proses alami seperti pencernaan, produksi makanan fermentasi, pertahanan terhadap bakteri jahat, serta fungsi imun tubuh.
Berikut Popmama.com bagikan manfaat bakteri baik untuk kesehatan tubuh, tak selamanya buruk!
Manfaat Bakteri untuk Kehidupan Manusia

1. Mendukung pencernaan dan penyerapan nutrisi
Bakteri baik di usus membantu memecah makanan yang kita makan menjadi bentuk yang dapat diserap tubuh. Mereka juga membantu menghasilkan nutrisi seperti vitamin K dan vitamin B tertentu.
2. Melindungi tubuh dari bakteri berbahaya
Komunitas bakteri yang seimbang di tubuh khususnya di usus mampu mengalahkan bakteri jahat dengan bersaing merebut tempat dan nutrisi sehingga kuman berbahaya sulit berkembang.
3. Meningkatkan sistem kekebalan tubuh
Bakteri baik membantu melatih sistem imun untuk mengenali yang berbahaya dan yang tidak berbahaya, sehingga tubuh bisa merespon infeksi dengan lebih baik. Sebagian bakteri juga memicu produksi senyawa yang memperkuat respon imun.
4. Pembuatan makanan fermentasi yang sehat
Beberapa jenis bakteri digunakan dalam industri makanan untuk membuat produk seperti yogurt, tempe, keju, dan kimchi. Proses fermentasi tidak hanya mengawetkan makanan tetapi juga menambah nutrisi dan rasa.
5. Daur ulang dan lingkungan
Di alam, bakteri berperan sebagai pengurai limbah alami, menguraikan bahan organik dan membantu siklus nutrisi di tanah dan air sehingga lingkungan tetap seimbang.
Bagaimana Bakteri Bekerja di Tubuh Kita
1. Simbiosis Mutualisme
Bakteri di tubuh kita hidup bersama dan saling menguntungkan. Kita memberi mereka nutrisi dan tempat tinggal, sementara mereka membantu fungsi tubuh yang tidak bisa dilakukan oleh sel manusia sendiri.
2. Komunitas Mikroba (Mikrobiota)
Tubuh manusia memiliki triliunan bakteri di berbagai bagian seperti kulit, mulut, dan terutama usus. Komunitas ini disebut mikrobiota atau mikrobioma.
3. Peran dalam Imunitas
Bakteri baik membantu sistem imun mempelajari dan mengenali patogen, serta menghasilkan substansi yang bisa menekan pertumbuhan bakteri berbahaya
4. Interaksi dengan Proses Fisiologis
Penelitian terbaru bahkan menunjukkan bakteri usus bisa memengaruhi fungsi metabolik dan sistem saraf melalui gut-brain axis (koneksi usus-otak) meskipun masih dalam kajian ilmiah lanjutan.
Dari mana datangnya bakteri baik?

1. Awal Kehidupan
Saat bayi lahir, terutama lewat persalinan normal, bakteri dari ibu mulai menempel di kulit dan usus bayi — membantu membangun mikrobioma yang sehat sejak dini.
2. Makanan Fermentasi & Probiotik
Produk seperti yogurt, kefir, tempe, kimchi, dan kombucha mengandung bakteri baik (probiotik) yang dapat memperkaya bakteri baik di usus.
3. Suplementasi Probiotik
Selain makanan, bakteri baik juga tersedia dalam bentuk suplemen yang bisa membantu menjaga keseimbangan mikrobiota, terutama setelah penggunaan antibiotik.
4. Lingkungan & Kontak Sehari-hari
Bakteri baik juga berasal dari interaksi dengan lingkungan, orang lain, dan makanan alami yang tidak terlalu diolah atau dibersihkan secara ekstrem.
Bakteri sesungguhnya bukanlah musuh, karena banyak di antaranya justru teman penting bagi kehidupan manusia. Itulah manfaat bakteri baik untuk kesehatan tubuh, tak selamanya buruk!


















